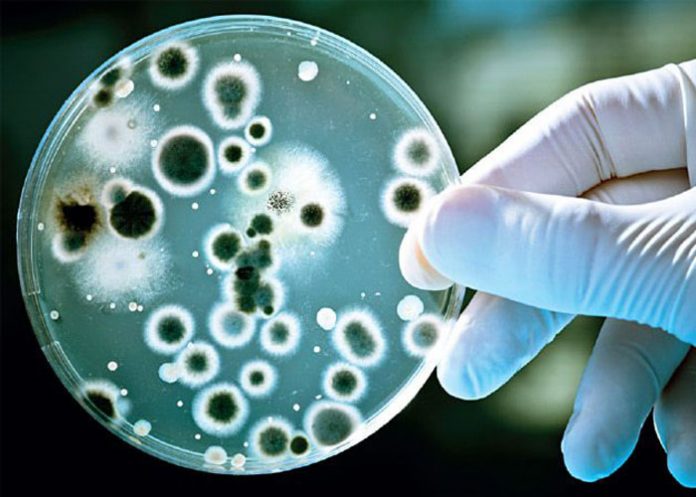
pascientes

Un grupo de científicos ha desarrollado una estrategia exitosa para combatir bacterias con alta resistencia o "superbacterias", como la "Pseudomonas aeruginosa", según un estudio publicado hoy en la revista especializada Science Translational Medicine.
Ante la falta de nuevos antibióticos efectivos contra ciertos tipos de bacterias, un equipo de la Universidad de Washington en Seattle (EE.UU.) cambió el enfoque y decidió crear un mecanismo para "engañar" a los microorganismos.
- Le puede interesar: Una nueva especie de pez de arrecife con colores fascinantes
En estudios con humanos y ratones, estas "superbacterias" confundieron con un nutriente el galio, un tipo de metal que causa estragos dentro de las bacterias y que finalmente acaba con ellas.
Los dos investigadores principales, Pradeep Singh y Christopher Goss, centraron su análisis en la "Pseudomonas aeruginosa", que causa infección en pulmones, tracto urinario y heridas, entre otros.
Los investigadores decidieron utilizar el galio porque es un metal similar al hierro, un nutriente esencial para las bacterias durante la infección.
"El cuerpo hace todo lo posible para mantener el hierro alejado de las bacterias, y los organismos infectados ponen en marcha sistemas especiales para importar hierro", dijo Singh, profesor de microbiología y medicina de la Universidad de Washington.
El galio interrumpe la maquinaria que las bacterias usan para fabricar nuevo ADN, y sin esto las bacterias no pueden multiplicarse.
En ratones, los investigadores encontraron que una sola dosis de galio cura las infecciones pulmonares letales.

Más tarde, estudiaron el funcionamiento del galio en 20 personas con fibrosis quística (FQ) e infecciones pulmonares difíciles de tratar, originadas por bacterias "Pseudomonas" resistentes a los antibióticos.
"Nuestro estudio preliminar en un pequeño grupo de personas con FQ sugiere que el galio es seguro y mejora la función pulmonar de los pacientes. Estos son resultados emocionantes, pero tenemos que hacer más estudios para determinar si el galio puede convertirse en un tratamiento de rutina y seguro", dijo Goss.